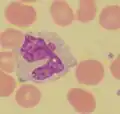
Monócitos

Coloração de May-Grünwald
A coloração de May-Grünwald é uma coloração histológica para a representação e diferenciação de várias células do sangue. [1]
Características
A coloração May-Grünwald é usada principalmente para esfregaços de sangue. Os núcleos celulares são corados. Incluem-se corantes azul de metileno e eosina Y, ou eosinato de azul de metileno, sendo ainda usada em variações a eosina B. O azul de metileno colore os ácidos nucleicos, como os dos cromossomos, motivo pelo qual a coloração de Wright também é usado para citodiagnóstico. A eosina colore áreas básicas no interior das células, tais como, por exemplo, proteínas de ligação ao ADN. A combinação da coloração de May-Grunwald com a coloração de Giemsa é chamada método ou coloração de May-Grunwald-Giemsa.
Formulação da solução corante
Pesa-se 0,3 g do corante em pó e transfere-se para um frasco cônico (frasco de Erlenmeyer) de 200 a 250 ml de capacidade. Adiciona-se 100 ml de metanol e aquece-se a mistura (preferencialmente em aquecedor elétrico) a 50°C. Deixar arrefecer o frasco até 20°C e agita-se várias vezes durante o dia. Depois de deixar repousar durante 24 h, filtrar a solução. Está então pronto para o uso, sendo que nenhum "amadurecimento" é requerido.[2]
-
 Granulócitos neutrófilos (em cima) e eosinófilos
Granulócitos neutrófilos (em cima) e eosinófilos -
 Granulócitos basófilos
Granulócitos basófilos -
Monócitos
Monócitos -
 Linfócitos
Linfócitos
Referências
- ↑ Irene Boll: Praktische Blutzelldiagnostik. Springer-Verlag, 2013, ISBN 978-3-642-74928-5, S. 165.
- ↑ K. A. Fasakin, G. R. A. Okogun , C. T. Omisakin , A. A. Adeyemi and A. J. Esan; Modified Leishman Stain: The Mystery Unfolds; British Journal of Medicine & Medical Research 4(27): 4591-4606, 2014. Em PDF